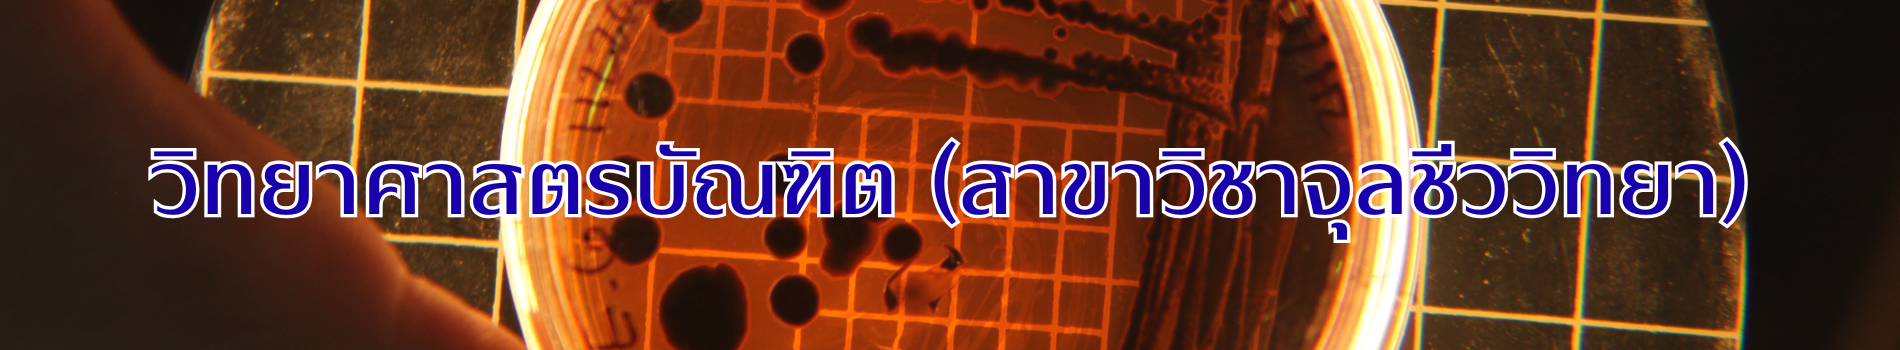
ภาพส่วนหัวหลักสูตร

ชื่อปริญญาภาษาไทย : วิทยาศาสตรบัณฑิต (จุลชีววิทยา)
ชื่อปริญญาภาษาอังกฤษ : Bachelor of Science (Microbiology)
อักษรย่อภาษาไทย : วท.บ. (จุลชีววิทยา)
อักษรย่อภาษาอังกฤษ : B.Sc. (Microbiology)
ไม่น้อยกว่า 120 หน่วยกิต
“มุ่งสร้างบัณฑิตจุลชีววิทยาด้วยกระบวนการเรียนรู้ควบคู่การปฏิบัติบนหลักการจุลชีววิทยาสีเขียว เพื่อการพัฒนาประเทศอย่างยั่งยืน ปฏิบัติงานได้ตามมาตรฐานสากล ใช่เทคโนโลยีดิจิทัลอย่างชาญฉลาด เป็นผู้ที่เรียนรู้ได้ตลอดชีวิต พร้อมปรับตัวให้สอดรับกับการเปลี่ยนแปลงของโลก ยึดมั่นในจรรยาบรรณวิชาชีพและรับผิดชอบต่อสังคม”
สถานการณ์ปัจจุบันของโลกมีการเปลี่ยนแปลงอย่างมากมาย ทั้งทางด้านสังคม วัฒนธรรม เทคโนโลยีและสิ่งแวดล้อม การเปลี่ยนแปลงเหล่านี้นำมาซึ่งปัญหาอันมีผลกระทบต่อวิถีชีวิตของมนุษย์ ทั้งการเกิดโรคอุบัติใหม่และโรคอุบัติซ้ำ ปัญหาเชื้อดื้อยา ปัญหาความมั่นคงทางอาหารและพลังงาน ประเทศที่เผชิญกับความท้าทายทางการพัฒนาทั้งทางเศรษฐกิจสังคมและวัฒนธรรม หลักสูตรวิทยาศาสตรบัณฑิต สาขาวิชาจุลชีววิทยา เป็นหลักสูตรที่มุ่งเน้นการสร้างฐานความรู้และทักษะปฏิบัติทางจุลชีววิทยาเพื่อการนำจุลินทรีย์มาใช้ประโยชน์และการควบคุมจุลินทรีย์ที่ก่อให้เกิดโทษ ในบริบทที่เกี่ยวข้องกับอุตสาหกรรมจุลินทรีย์ด้านการผลิตและแปรรูปอาหาร การผลิตผลิตภัณฑ์ชีวภาพ
ชีวภัณฑ์จุลินทรีย์ พลังงานชีวภาพ การแพทย์ เภสัชกรรม เกษตรกรรมและสิ่งแวดล้อม
PLO 1 ประยุกต์ความรู้ทางจุลชีววิทยาในระบบการผลิตของอุตสาหกรรมอาหาร หรืออุตสาหกรรมที่เกี่ยวข้องและสนับสนุนกับอุตสาหกรรมอาหาร เพื่อการผลิตและพัฒนาผลิตภัณฑ์โดยยึดหลักความปลอดภัยทางชีวภาพและจุลชีววิทยาสีเขียว
PLO 2 วิเคราะห์จุลินทรีย์ในห่วงโซ่คุณค่าของอุตสาหกรรมอาหารได้ด้วยวิธีมาตรฐานสากล
PLO 3 ค้นคว้าองค์ความรู้หรือนวัตกรรมจากแหล่งข้อมูลที่เชื่อถือได้ทุกครั้งเมื่อมีการวิเคราะห์จุลินทรีย์และพัฒนาผลิตภัณฑ์ในอุตสาหกรรมอาหาร
PLO 4 วิเคราะห์ข้อมูลหรือชุดข้อมูลได้ด้วยการใช้ทักษะดิจิทัลและโปรแกรมวิเคราะห์ทางด้านชีวสารสนเทศ
PLO 5 ยึดหลักจริยธรรมของนักวิทยาศาสตร์และจรรยาบรรณแห่งวิชาชีพ โดยไม่คัดลอกผลงานทางวิชาการและรายงานผลการปฏิบัติงานด้านวิชาชีพตามความเป็นจริง
PLO 6 แสดงบุคลิกภาพของการมีทัศนคติและแนวคดิแบบยืดหยุ่น เป็นผู้นําและผู้ตามที่ดีในสถานการณ์ที่ต้องปฏิบัติงานร่วมกับผู้อื่น
PLO 7 ใช้กระบวนการคิดอย่างเป็นระบบในการตัดสินใจและแก้ไขปัญหาในการปฏิบัติงานทางด้โานจุลชีววิทยา
22,500 บาท
ชื่อปริญญาภาษาไทย : วิทยาศาสตรบัณฑิต (จุลชีววิทยา)
ชื่อปริญญาภาษาอังกฤษ : Bachelor of Science (Microbiology)
อักษรย่อภาษาไทย : วท.บ. (จุลชีววิทยา)
อักษรย่อภาษาอังกฤษ : B.Sc. (Microbiology)
สร้างบัณฑิตที่มีความรู้ทางด้านจุลชีววิทยา ที่สามารถปฏิบัติงานตามหลักมาตรฐานสากล สามารถสื่อสารภาษาอังกฤษได้อย่างมีประสิทธิภาพ คิดเป็น ทำเป็น มีความซื่อสัตย์ สุจริต และพร้อมเสียสละเพื่อส่วนรวม
สถานการณ์ปัจจุบันของโลกมีการเปลี่ยนแปลงอย่างมากมาย ทั้งทางด้านสังคม วัฒนธรรม เทคโนโลยีและสิ่งแวดล้อม การเปลี่ยนแปลงเหล่านี้นำมาซึ่งปัญหาอันมีผลกระทบต่อวิถีชีวิตของมนุษย์ ทั้งการเกิดโรคอุบัติใหม่และโรคอุบัติซ้ำ ปัญหาเชื้อดื้อยา ปัญหาความมั่นคงทางอาหารและพลังงาน ประเทศที่เผชิญกับความท้าทายทางการพัฒนาทั้งทางเศรษฐกิจสังคมและวัฒนธรรม หลักสูตรวิทยาศาสตรบัณฑิต สาขาวิชาจุลชีววิทยา เป็นหลักสูตรที่มุ่งเน้นการสร้างฐานความรู้และทักษะปฏิบัติทางจุลชีววิทยาเพื่อการนำจุลินทรีย์มาใช้ประโยชน์และการควบคุมจุลินทรีย์ที่ก่อให้เกิดโทษ ในบริบทที่เกี่ยวข้องกับอุตสาหกรรมจุลินทรีย์ด้านการผลิตและแปรรูปอาหาร การผลิตผลิตภัณฑ์ชีวภาพ ชีวภัณฑ์จุลินทรีย์ พลังงานชีวภาพ การแพทย์ เภสัชกรรม เกษตรกรรมและสิ่งแวดล้อม
24,000 บาท